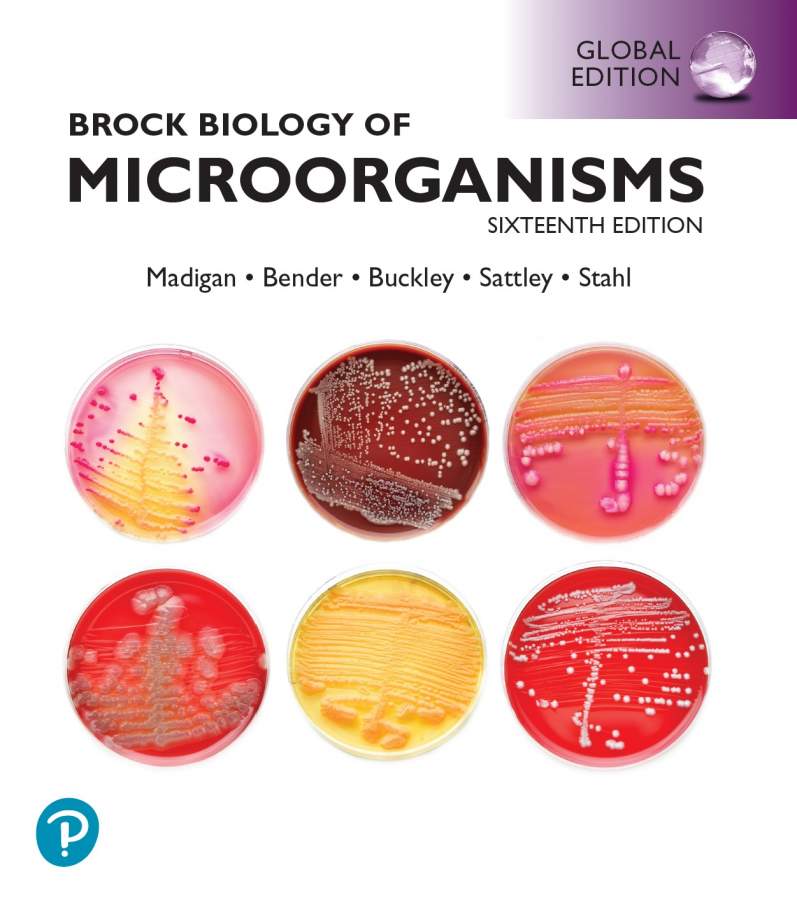

最棒的微生物教材《Brock Biology of Microorganisms》2021年第16版PDF 网盘链接
brock biology of microorganisms sets the standard for accuracy, impeccable scholarship, a visually stunning art program, and the use of cutting edge research to illustrate basic concepts. the text guides students through the six major themes of microbiology — evolution, cell structure and function, metabolic pathways, information flow and genetics, microbial systems, and the impact of microorganisms — as outlined by the american society for microbiology conference on undergraduate education (asmcue). this robust and modern approach takes students through the genomics revolution and “omics” maze that has transformed microbiology and shares powerful tools that microbiologists use to probe deeper and further into the microbial world than ever before.
the 16th edition expands the extraordinary art program to ensure students experience microbiology as a visual science while providing an overview of the microbial world with basic principles that students all need to master. each chapter’s theme focuses on a recent discovery that connects students with the most current science and engages them with exciting, real-world topics.

下载链接:
https://url97.ctfile.com/d/17939197-29056621-ff80d0
访问码:3136
[ Last edited by nivea2016 on 2021-8-13 at 17:06 ]
返回小木虫查看更多
京公网安备 11010802022153号